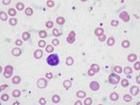
營養性胚胎病

概述
營養性胚胎病,除一部分可能由遺傳因子支配所致外,大部分是由於親代不合理的飼養因素所致。病因主要有以下幾種情況:①維生素缺乏症,特別是維生素A、維生素D、維生素E、維生素B1、維生素B2、的不足。②蛋白質和某些雞胚生長發育有關胺基酸的缺乏。③礦物質和微量元素不足。④某些營養成分過多。⑤蛋內含有抗生素,可使禽胚的生物素(一種輔酶)失去生理作用,擾亂了某些物質的正常代謝,影響胚胎髮育。
營養性胚胎病
營養性胚胎病營養性胚胎主要特徵為骨骼端軟骨早期發生變性,因而產生胚胎肢體短縮,足肢和頸變曲,喙部呈“鸚鵡喙”,骨的生長發育受阻。蛋白未被完全吸收,蛋黃高度粘稠。同時其他組織器也相應發生營養養不良現象。
維生素A缺乏症
孵化初期死胚甚多,並且胚胎生長遲緩。死胚腎臟腫脹,胸膜、心包膜、腸管、腸系膜及卵黃囊內有結晶鹽類沉著,以腎臟為最明顯。出殼時間推遲,皮膚和絨毛的顏色欠佳,有色素沉著。眼乾燥,眼瞼中有乾酪樣物。原因是種雞日糧中缺乏維生素A。可取蛋黃、胚胎或幼禽的肝組織進行維生素A的含量測定。
維生素D缺乏症
種蛋殼薄,蛋白較稀,蛋黃可移動性較大。入孵10天后胚胎髮生粘液性水腫病,胚胎皮膚出現囊泡狀水腫,其內充滿漿液,透明無色或淡黃色,皮下組織增生,有時腿爪短小,肝臟脂肪浸潤。胚胎在10~16胚齡死亡較多。孵出的雛禽體弱,水腫現象廣泛發生,骨質不良,10日齡可發生佝僂病。原因是種雞日糧中缺乏維生素D,鈣磷不足或鈣磷比例不當或當照不足。
維生素E缺乏症
 營養性胚胎病
營養性胚胎病此病極少見,僅見於種雞日糧配合極不合理的情況下。該病於孵化的第1周內胚胎的死亡率最高。發生此病時蛋黃中的胚層腫大,導致胎盤內的血管受到壓縮而出現胚體血液瘀積或出血情況。還可使胚胎的眼睛晶狀體混濁和角膜出現斑點。
維生素B1缺乏症
該病多發生鴨特別是母鴨在放牧期間大量採食魚蝦、蜆、蟛蜞和貝類,而穀類飼料(糠麩)補充不足時最易發生。幼雛出殼時間延長,往往只能將蛋啄一小孔而無力破殼,最後悶死於蛋內。若能孵出即出現神經症狀。
維生素B2缺乏症
胚胎於孵化的第9~14日死亡最高。死胚表現皮膚結節狀絨毛,軀體短小、水腫、貧血,腎臟變性,輕度短肢,關節明顯變形,頸部彎曲等病理變化。具有上述病理表現的胚胎有時也能照常孵出,但多數帶有先天性麻痹症狀。
維生素B12缺乏症
胚胎於孵化第16~18天時出現很高的死亡率。特徵性病變為胚胎生長緩慢,短喙,彎趾,皮膚呈瀰漫性水腫,肌肉萎縮,心臟擴大及形態異常,甲狀腺腫大,肝臟脂肪變性,卵黃囊、心臟和肝臟均有出血。
短肢性營養不良
 營養性胚胎病
營養性胚胎病種禽飼餵非全價的蛋白性飼料,生物素、葉酸、膽鹼、錳等缺乏能引起此種胚胎病。胚體短小,足肢短而彎曲,頸亦彎曲,喙呈特徵性的“鸚鵡嘴”。孵出的幼雛出現以足肢關節變化為特徵的骨短粗病,並且其孵化率也顯著下降。
肌胃角質炎(抗肌胃腐蝕素缺乏)
多出現在胚胎髮育後期或剛出殼的雛禽。病變表現為肌胃角質層表面有裂痕、損傷及微小的出血,有時甚至發生潰瘍;嚴重時,發炎的角質層易於剝落。
鋅缺乏症
骨骼異,可能無翼和無腿,絨羽呈簇狀。
硒缺乏症
孵化率降低,皮下積液,滲出性素質。

